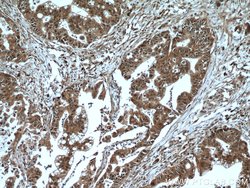
GSTO1 Rabbit anti-Human, Mouse, Rat, Polyclonal, Proteintech 20 &mu;L | Buy Online | Proteintech | Fisher Scientific

missing translation for 'onlineSavingsMsg'
Learn More
Learn More
Description
This antibody detects both monomer (27-30 kDa) and dimer forms of GSTO1 (54-64 kDa).
GSTO1 (glutathione S-transferase omega 1), also known as p28 or GSTTLp28, is a 241 amino acid protein that localizes to the cytoplasm and contains both an N-terminal and a C-terminal GST domain. Expressed ubiquitously with highest expression in heart, liver and skeletal muscle, GSTO1 exists as a homodimer that functions as both a glutathione-dependent thiol transferase and a dehydroascorbate reductase. Specifically, GSTO1 catalyzes the reaction of glutathione with a wide variety of organic compounds to form thioethers, a process that is essential for the metabolism and detoxification of a variety of xenobiotics and carcinogens. Human GSTO1 shares 70% sequence homology with its rodent counterpart, suggesting a conserved role between species. Polymorphisms in the gene encoding GSTO1 may be associated with the development of childhood acute lymphoblastic leukemia, Parkinson′s disease and Alzheimer disease.
Specifications
Specifications
| Antigen | GSTO1 |
| Applications | Immunoprecipitation, Western Blot, Immunofluorescence, Immunohistochemistry (Paraffin), Immunocytochemistry |
| Classification | Polyclonal |
| Concentration | 0.3 mg/mL |
| Conjugate | Unconjugated |
| Formulation | PBS with 50% glycerol and 0.02% sodium azide; pH 7.3 |
| Gene | GSTO1 |
| Gene Accession No. | O09131, P78417, Q9Z339 |
| Gene Alias | GSTO 1, GSTO1, GSTTLp28, P28 |
| Gene Symbols | GSTO1 |
| Show More |
Product Title
By clicking Submit, you acknowledge that you may be contacted by Fisher Scientific in regards to the feedback you have provided in this form. We will not share your information for any other purposes. All contact information provided shall also be maintained in accordance with our Privacy Policy.
Spot an opportunity for improvement?